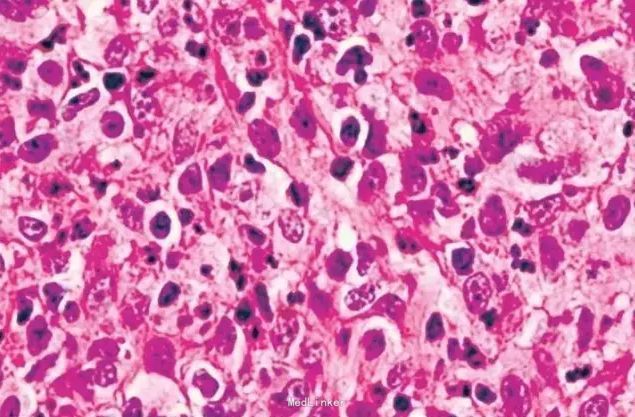

下载或打开 医联APP 查看完整评论
立即下载
打开APP
麻风病?淋巴瘤样丘疹病?
主诉 病史
患者男,30岁,面部、躯干、四肢丘疹、结节4年余。
查体 辅查
体检:左侧耳大神经,双侧腓总神经粗大。皮肤科检查:面颈部、躯干、腋下、四肢散在丘疹、结节、部分破溃结痂;双侧眉毛外2/3脱落,双侧腋毛完全脱落。部分皮疹温度觉减退,痛觉及触觉未见明显异常。皮肤组织病理检查:表皮大致正常,真皮浅中层可见结节、团灶状细胞浸润,由散在的间变性大细胞混合淋巴细胞、组织细胞、中性粒细胞、嗜酸性粒细胞等组成,其中间变性大细胞胞质丰富,核大,核仁明显,胞浆透亮,偶见核分裂。免疫组化结果:CD3、CD4、CD5、CD30阳性;CD8、CD20阴性。两次抗酸染色(-)。

诊断 处理
诊断:淋巴瘤样丘疹病。
随访 讨论
讨论:本例皮疹表现、良性临床病程、组织病理及免疫组化检查结果均符合淋巴瘤样丘疹病诊断。但该患者同时伴有眉毛、腋毛脱落,左侧耳大神经,双侧腓总神经粗大、温度觉减退等类似麻风的临床表现,易误诊为麻风,最终经组织病理及免疫组化得以确诊。
发布于 15-11-28 00:52
